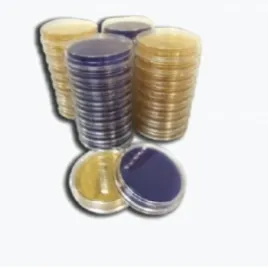

Контактная чашка Агар Сабуро с декстрозой (SDA) и нейтрализатором (одинарный пакет)
Информация
SURCHECK SDA w/NEUTRALISANT Контактная чашка Агар Сабуро с декстрозой (SDA) и нейтрализатором
Среда используется для выделения дрожжей и плесневых грибков при проведении микробиологического контроля и определения эффективности дезенфекции различных поверхностей, тары и оборудования
Категория:
Microorganism: Aspergillus brasiliensis, Candida albicans, Дрожжи и плесневые грибы
Производитель:
Микроорганизм | Инокулят (КОЕ) | Результаты | |
Рост | Реакция | ||
Candida albicans ATCC 10231 | 10-100 | Хороший | Хорошая |
Aspegillus brasiliensis ATCC 16404 | 100-1000 | Хороший | Хорошая |
Tемпература хранения 2-12°С
Срок хранения 5 месяцев
Tемпература хранения c гамма облучением 2-25°С
Срок хранения c гамма облучением 4 месяца
Нейтрализующие добавки TL (Tween 80- лецитин)
Микробиологический контроль: инкубировать 5 дней при 25 ±2 ° С. Рост наблюдается после 48 часов инкубации
Упаковка содержит 10 штук контактных чашек